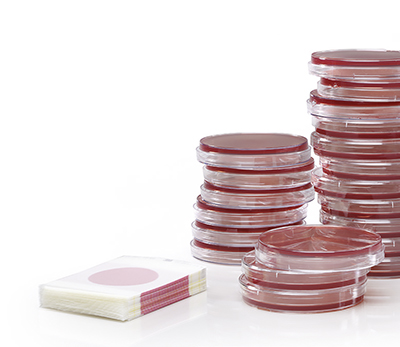

Redaktionelle Beiträge
Redaktionelle Beiträge

Mit guter Umweltpolitik erfolgreich sein
Wir sind ein Familienunternehmen und legen bei der strategischen Ausrichtung seit jeher Wert auf Langfristigkeit. Wir tragen dabei Sorge zu den Ressourcen und übernehmen Verantwortung. Nachhaltigkeit und Verantwortung heisst für uns in der Praxis, dass wir ständig auf der Suche nach neuen Materialien und Lösungen sind, welche unseren ökologischen Ansprüchen gerecht werden.

ProLiner-Musteretiketten in zwei Materialvarianten können Sie gerne unter 081 750 34 34 oder Diese E-Mail-Adresse ist vor Spambots geschützt! Zur Anzeige muss JavaScript eingeschaltet sein! bestellen.
Wir präsentieren Ihnen hier ein neues innovatives Etiketten-Haftmaterial, das einzigartig in seiner Art ist. Der nachhaltige ProLiner PP30 von UPM Raflatac.
Etimark AG ist damit der Partner in der Verpackungs-Herstellung, der Ihnen zur Seite steht, wenn auch Sie Ihre nachhaltigen Unternehmensziele umsetzen möchten.
Fangen Sie schon heute an! Die Musteretiketten erhalten Sie unter Telefon 081 750 34 34.
Innovation ProLiner PP30
Der ProLiner PP30 ist der bisher dünnste Träger für Papier- und Kunststoffetiketten des Herstellers UPM Raflatac und bietet viele Vorteile:
bis zu 20% mehr Etiketten/Rolle
bis zu 6000 Laufmeter/Rolle – weniger Rollenwechsel,
geringer Zeitaufwand
mehr auf der Rolle heisst auch weniger Rollen für die
gleiche Menge – weniger Lagerbedarf
leichter, daher geringere Transportkosten
Trägerabfall ist 100% rezyklierbar
finanzielle Rückvergütung über RafCycle
und die Möglichkeit, der Umwelt etwas Gutes zu tun,
das sich finanziell auszahlt!
Was wird daraus?
Es gibt ein gutes Gefühl, wenn man weiss, dass man Gutes tun kann und die Umwelt schont. Mit dem wiederverwerteten Abfall nehmen Sie einen wichtigen Einfluss auf die Umwelt. Die Abfälle werden zur Herstellung von strapazierfähigen Erzeugnissen für Terrassen und Fassaden verwendet und erhalten damit ein zweites Leben.
Etimark AG
Die Etimark AG wurde 1978 gegründet und wird heute in zweiter Generation von den Brüdern Udo und Marco Schulz geführt. Das Schweizer Unternehmen mit Sitz im rheintalischen Grabs ist spezialisiert auf massgeschneiderte Verpackungs-Drucklösungen, die alle Anforderungen an Qualität, Sicherheit, Funktionalität und Ästhetik erfüllen – alles in modernster und kostenoptimierter Produktion. Langjährige Erfahrung, viel Know-how im UV-Flexodruck und in der hauseigenen Druckvorstufe sowie Leidenschaft zur Perfektion – auf dieser Basis werden Etiketten, Stanzdeckel (Platinen) und flexible Verpackungen in einwandfreier Druckqualität und kompromisslos genauer Farbabstimmung produziert. Die ganze Produktion ist nach dem Hygienestandard BRC/IOP zertifiziert.

Mit 4 UV-Flexo-8-Farben-Maschinen und 1 UV-Flexo-6-Farben-Maschine ist der Drucksaal perfekt ausgestattet. Keine Maschine ist älter als 6 Jahre.

Mit 8 leistungsfähigen Stanzautomaten gewährleisten wir höchste Flexibilität.
Produktgruppen der Etimark
FlexoEtiketten
Etiketten für ein hochwertiges Produktoutfit oder einen informativen Auftritt in Papier, Kunststoff, Metall-Look, No-Label-Look und Retro-Design oder mit Spezialeffekten.
FlexoDeckel
Stanzdeckel für die Milch-, Nahrungsmittel- und Tiernahrungsindustrie aus Aluminium, PET oder anderen Monofolien, in unterschiedlichen Dicken, in Standard- oder Sonderformaten.
FlexoVerpackungen
Rollengewickelte Folien für Kosmetik- und Körperpflegeprodukte, Gross-Metzgereien und -Bäckereien.
Etimark AG
Fabrikstrasse
9472 Grabs
| Telefon | 081 750 34 34 |
| Fax | 081 750 34 35 |
Diese E-Mail-Adresse ist vor Spambots geschützt! Zur Anzeige muss JavaScript eingeschaltet sein!
www.etimark.ch
Eurofins Scientific AG Schweiz
Ihr Partner-Labor für Lebensmittel, Futtermittel, Deklaration, Pharma, Kosmetika sowie Audits & Monitoring. Das Rundum-sorglos-Paket aus einer Hand.




Sie erreichen uns an 2 Standorten:

Wir helfen Ihnen, gesetzliche Auflagen zu erfüllen, Risiken zu vermindern und Ihre Markenwerte zu schützen.

Durch unsere Verbindungen im internationalen Eurofins-Netzwerk können wir Ihnen in vielen Fällen auch Lösungen für spezielle Analysenprobleme anbieten.
Hauptsitz und Labor
Zweigniederlassung Westschweiz
Parkstrasse 10
5012 Schönenwerd
Anne Barbet
| Telefon | Mobil 076 394 71 81 |
| Fax | 062 858 71 09 |
Diese E-Mail-Adresse ist vor Spambots geschützt! Zur Anzeige muss JavaScript eingeschaltet sein!
www.eurofins.ch
30 Jahre 3M™ Petrifilm Zählplatten
Kolibakterien, Schimmelpilze, Hefen – krankheitserregende Keime möchte niemand auf seinen Lebensmitteln haben. Daher spielt in der Lebensmittelindustrie die mikrobiologische Überwachung der Produktionsprozesse eine wichtige Rolle.
Vor 30 Jahren brachte 3M ein Produkt auf den Markt, das die Untersuchung von Lebensmitteln auf eine Keimbelastung erheblich erleichtert: 3M™ Petrifilm™ Zählplatten.
Die Entwicklung des Produkts ist eine typische 3M Erfindergeschichte.
Entscheidende Zutaten waren die Idee und Initiative eines Forschers, Robert L. Nelson, das Zusammenführen verschiedener 3M Technologien, die Zusammenarbeit mit Forschern aus anderen Bereichen und ein langer Atem. Das Ergebnis sieht einfach und unspektakulär aus, ist aber ein ziemlich komplexes Produkt.

Flach wie ein Foto und sofort einsatzbereit
Das gebrauchsfertige mikrobiologische Testverfahren basiert auf einer Kunststoff-Folie, die mit einem kaltwasserlöslichen Gel und einem Nährmedium beschichtet ist. Während bei traditionellen Methoden, etwa dem Plattengussverfahren, aufwendige Vorbereitungsarbeiten anfallen, ist der Petrifilm sofort einsatzbereit: Die Auszählplatte ist flach wie ein Foto und wird fix und fertig aus einer Packung entnommen. Nach Anheben der Deckfolie aus Kunststoff pipettiert man 1 ml der Probe mittig auf das Nährmedium und deckt es anschliessend wieder ab. Der Petrifilm wird dann in einem Inkubator bebrütet. Der entscheidende Vorteil, gerade im kleinen Labor, liegt hierbei im geringen Platzbedarf, der um 92 Prozent niedriger ist als bei der Petrischale. Auch unter dem Aspekt der Nachhaltigkeit ist das sehr wichtig.
Aufwendige Prozessschritte einsparen
Mit dem Petrifilm lassen sich viele aufwendige Prozessschritte wie Kochen, Abmessen und Sterilisieren einsparen, die bei anderen Verfahren erforderlich sind und viel Arbeitszeit beanspruchen. Die Nährböden können ausserdem aufgrund ihrer Haltbarkeit und ihres minimalen Platzbedarfs problemlos in grösseren Mengen bevorratet werden.
Vielfältige Anwendungen
Heute gibt es über ein Dutzend verschiedene 3M Petrifilm Auszählplatten und es werden immer weitere entwickelt. Durch internationale Validierungen sind sie als amtliche Verfahren zugelassen. Neben den Anwendungen für Lebensmittel ist auch eine Produktlinie für die Testung von Wasser erhältlich. Auch diese verfügt über alle Vorteile der gebrauchsfertigen Petrifilme und vereinfacht die Durchführung von Wasserproben erheblich.
Neuinnovationen gibt es von 3M auch im Bereich Pathogen-Testung. Hierfür hat 3M ein Gerät, das 3M Molecular Detection System (MDS) entwickelt, welches zuverlässig und auf einfachste Weise pathogene Keime auf DNA-Basis nachweist. Inhibitionen durch gewisse Lebensmittel sind hier kein Problem mehr.
Die 3M™ Petrifilm Zählplatten (oben) benötigen sehr viel weniger Platz als die herkömmlichen Petrischalen
Foodtech AG
Wermatswilerstrasse 8
8610 Uster
| Telefon | 044 994 44 88 |
| Fax | 044 994 44 89 |
Diese E-Mail-Adresse ist vor Spambots geschützt! Zur Anzeige muss JavaScript eingeschaltet sein!
www.foodtech.ch
3-in-1 – Fördern, CIPen und Produktzuführen
HYGHSPIN-Schraubenspindelpumpen sind in der Lage, Produkte mit einer Viskosität bis zu 1.000.000 cPs problemlos zu fördern. Ist jedoch, wie in der Lebensmittelindustrie häufig anzutreffen, das Fördermedium überhaupt nicht fliessfähig, können diese Produkte nur mit Hilfe zwangsweiser Zuführung in die Pumpaggregate gelangen. Zu diesem Zweck werden in der Regel externe Extruder eingesetzt. Dieses Gesamtsystem ist teuer und schlecht zu reinigen. Sobald das Produkt dann in der Förderkammer der Pumpe ist, greifen die normalen Mechanismen zur Druckerhöhung. An diesem Punkt setzt die weiterentwickelte Konstruktion der HYGHSPIN-Pumpen an. Für alles, was nicht frei fliesst, wurde eine Förderschrauben-Extruder-Einheit entwickelt. Die Zuführung des Fördermediums erfolgt im Extruderbereich, der unterhalb des Einfülltrichters positioniert ist, die Druckerhöhung im eigentlichen Pumpenbereich mit den für die jeweilige Anwendung individuell ausgelegten Förderschrauben. Diese innovative Lösung ermöglicht es Verarbeitern ihre Produkte sehr schonend zu fördern, auf die externen Extruder zur «Zufütterung» zu verzichten und in der gewohnten Weise mit derselben Pumpe die CIP-Reinigung durchzuführen.

Neuentwickelte Förderschrauben-Extruder-Einheit
Verfügbar für die Pumpengrössen 70, 90 und 125
Die neuartige Förderschrauben-Extruder-Einheit ist für die Pumpengrössen HYGHSPIN 70, HYGHSPIN 90 und HYGHSPIN 125 verfügbar. Die maximale Fördermenge liegt bei ca. 20 m3/h, der Differenzdruck in der Standardausführung bei maximal 10 bar. Anwender können auf die bewährten HYGHSPIN-Vorteile vertrauen. Die Pumpe entspricht den Konstruktionsprinzipien des Hygienic Design. Sie sind vollständig aus Edelstahl hergestellt. Die berührungslos laufenden Förderschrauben garantieren eine absolut schonende und pulsationsarme Förderung. Die Gleitringdichtungen liegen voll im Strömungsbereich und werden so hervorragend gekühlt und gereinigt. Alle produktberührenden Elastomere sind als leicht zu reinigende FDA-konforme Formringe ausgeführt.
HYGHSPIN 90 H mit Trichteröffnung für nicht-fliessfähige Fördermedien
HänyTec AG
Lättfeld 2
6142 Gettnau
| Telefon | 062 544 33 00 |
| Fax | 062 544 33 10 |
Diese E-Mail-Adresse ist vor Spambots geschützt! Zur Anzeige muss JavaScript eingeschaltet sein!
www.haenytec.ch